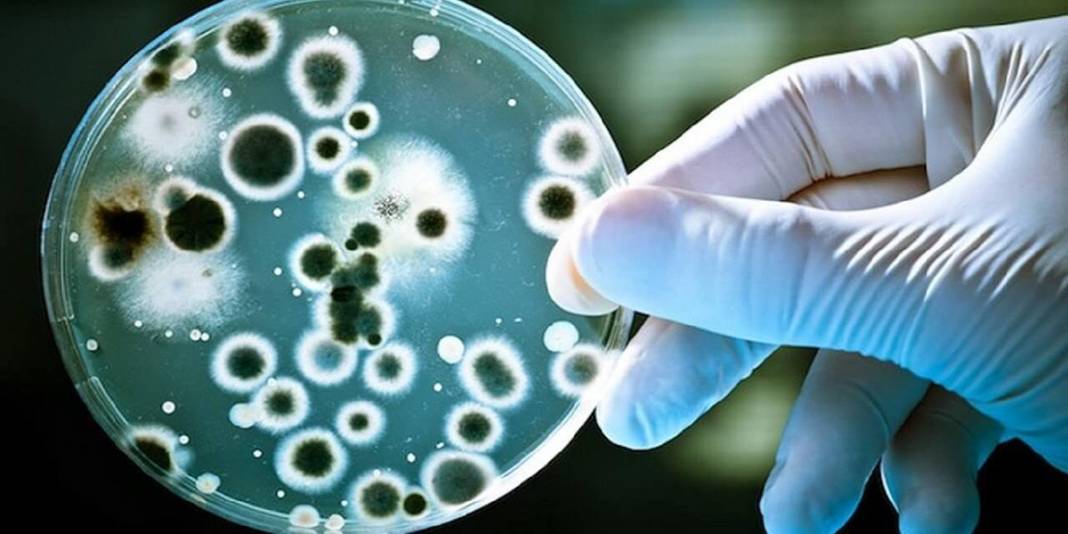
Sibirya'da donmuş toprakta bulundu! Mikroskobik Drakula 24 bin yıldır yaşıyor 3
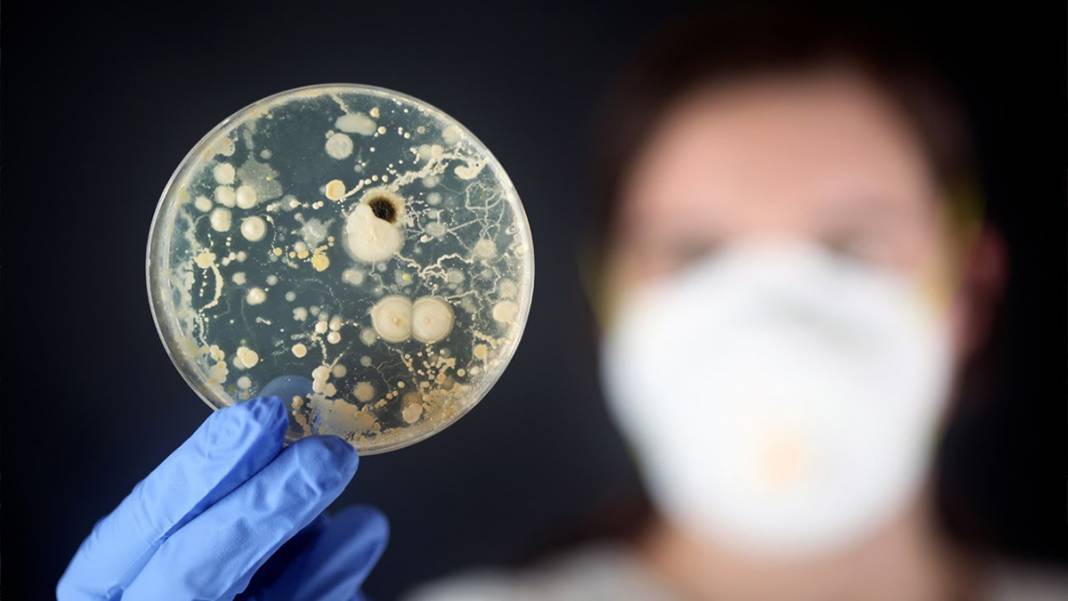
Sibirya'da donmuş toprakta bulundu! Mikroskobik Drakula 24 bin yıldır yaşıyor 4
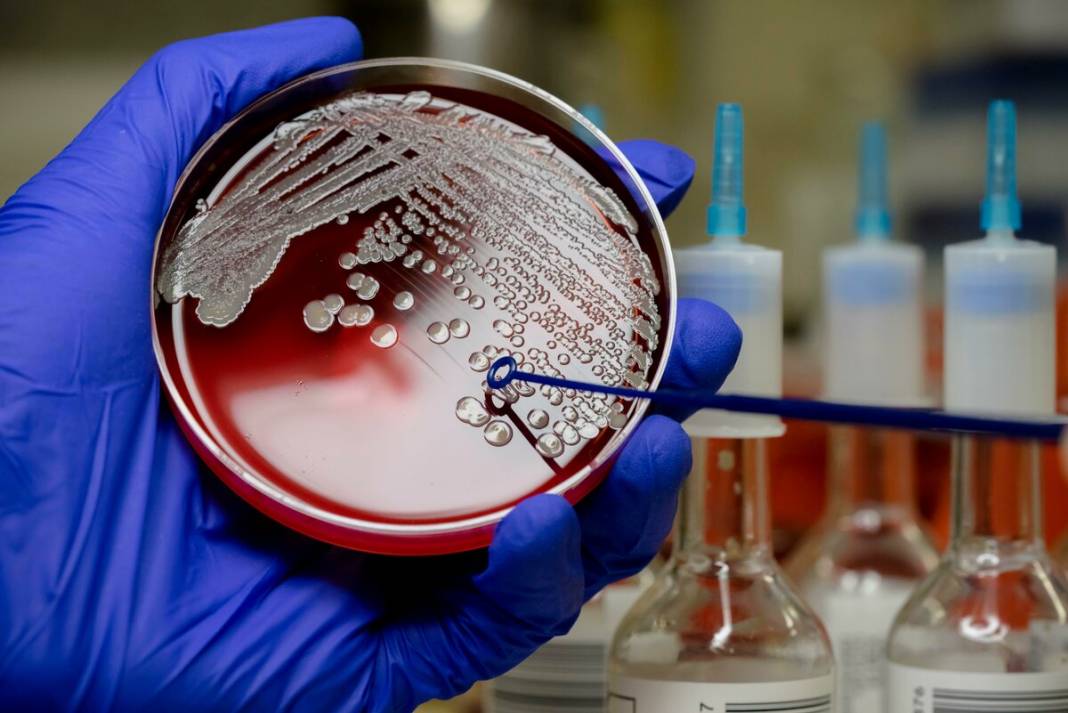
Sibirya'da donmuş toprakta bulundu! Mikroskobik Drakula 24 bin yıldır yaşıyor 6
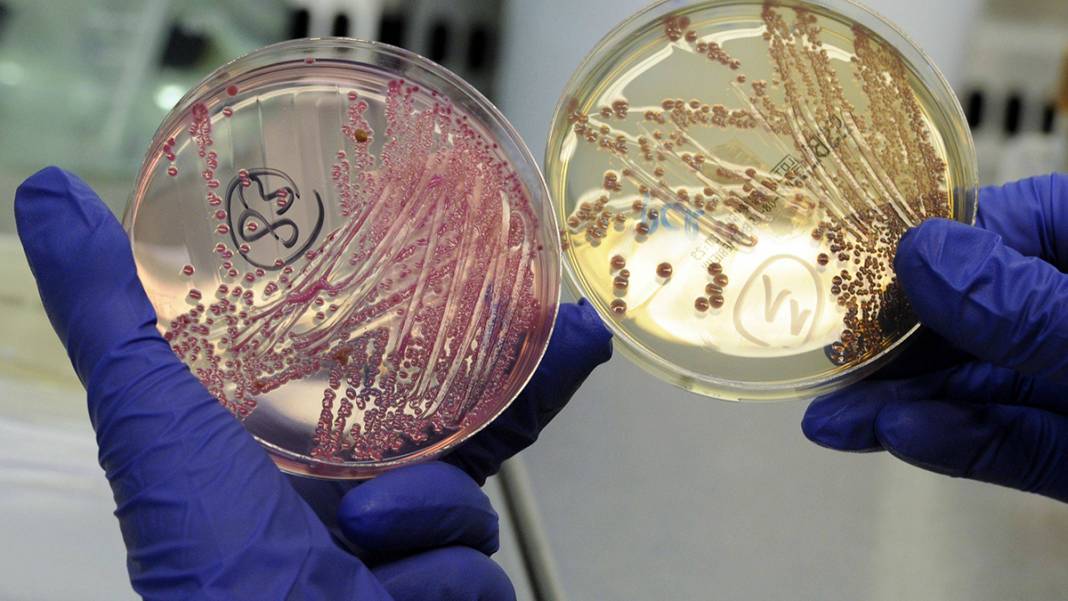
Sibirya'da donmuş toprakta bulundu! Mikroskobik Drakula 24 bin yıldır yaşıyor 7

Rusya'da bulunan Pushchino Bilimsel Araştırmalar Merkezi araştırmacıları, Sibirya bölgesindeki donmuş toprak tabakasından alınan donmuş toprak numunesinde tam 24 milyon yıldır yaşayan mikroskobik canlı bulundu.

Rusya'da bulunan Pushchino Bilimsel Araştırmalar Merkezi araştırmacıları, Sibirya bölgesindeki donmuş toprak tabakasından alınan donmuş toprak numunesinde tam 24 milyon yıldır yaşayan mikroskobik canlı bulundu.

Kont Drakula'yı hatırlatan mikroskobik canlının kriptobiyoz yaşam formunda hayatta kaldığı belirtildi.
Bilim insanları, Sibirya bölgesinde yürüttükleri çalışmalarda topladıkları donmuş toprak numunesinde "Bdelloid rotifer" isimli mikroskobik canlının bulunduğunu tespit etti.
Sondaj yolu ile elde edilen numunenin içerisinde donmuş halde bulunan çok hücreli organizmayı inceleyen araştırmacılar, canlının yaşam fonksiyonlarının devam ettiğini belirledi.

Organizmanın yaşını belirlemek üzere ileri radyo-karbon testlerine tabi tutan bilim insanları, canlının 24 bin yıllık olduğunu anladı.
Araştırma ekibinden Stas Malavin, çalışmanın çok hücreli hayvanların kriptobiyoz halinde on binlerce yıl yaşayabileceklerini ispat eden çok güçlü bir kanıt olduğunu ifade etti.
Bazı basit organizmaların, aşırı sıcak, aşırı soğuk veya zehirli ortam gibi yaşamsal faaliyetlerin sürdürülmesinin zor olduğu ortamlarda metabolizmalarını neredeyse duracak seviyeye getirme anlamına gelen kriptobiyoz halinde hayatta kalmayı başardığı biliniyor.

Bilim insanları, daha önce bazı basit kurtçuk ve bitki türlerini donmuş toprak örnekleri içerisinde tespit etmiş ve donmuş halde hayatta kalabildiklerini rapor etmişti.
